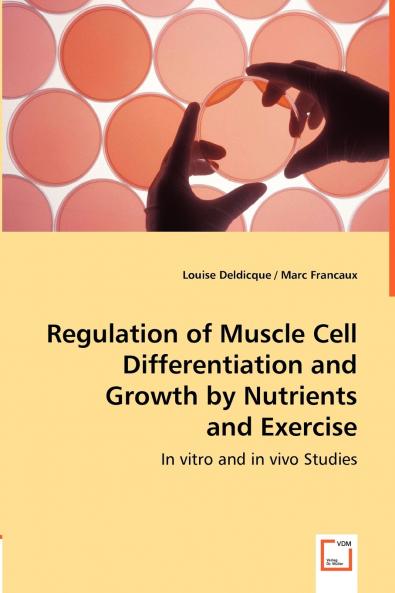
Regulation of Muscle Cell Differentiation and Growth by Nutrients and Exercise

English
Paperback
₹8122
(All inclusive*)
Delivery Options
Please enter pincode to check delivery time.
*COD & Shipping Charges may apply on certain items.
Review final details at checkout.
Looking to place a bulk order? SUBMIT DETAILS
About The Book
Description
Author(s)
A significant advance in understanding skeletal muscle adaptation to physical training has been the observation that nutrients and exercise work in synergy to enhance muscle protein synthesis. Physical activity triggers an adaptive response to which nutrition provides the necessary building blocks for an optimal response. The aim of the present work is to contribute to the understanding of the molecular events induced by exercise or nutrients (creatine and amino acids) to create the adaptive environment and to induce the cellular adaptation and growth respectively. Amino acids influence the expression of muscle-specific genes and regulate mTOR a kinase implicated in the control of protein translation. We have highlighted that changes in the phosphorylation state of mTOR do not necessarily lead to changes in the rate of protein synthesis. In vitro creatine largely enhances protein anabolism and cell differentiation. We have identified the p38 and the Akt/PKB pathways as mediators of these effects. Nevertheless we were unable to confirm the existence of similar events in human skeletal muscle in vivo.
Delivery Options
Please enter pincode to check delivery time.
*COD & Shipping Charges may apply on certain items.
Review final details at checkout.
Details
ISBN 13
9783836492355
Publication Date
-12-06-2013
Pages
-264
Weight
-362 grams
Dimensions
-150x220x14.16 mm